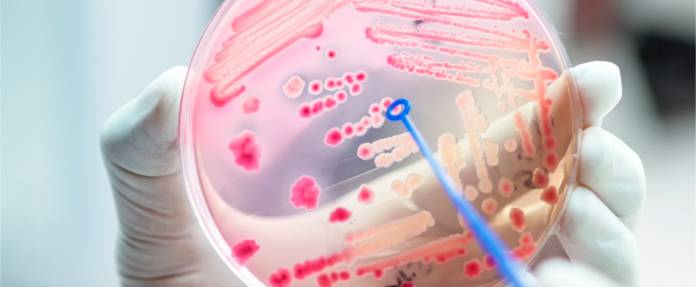

Wann können Abszesse zu einer Blutvergiftung führen?
Eine Sepsis (Blutvergiftung) geht in der Regel von einer örtlich umschriebenen bakteriellen Infektion aus. Zu solchen Infektionen gehören Abszesse. Abszesse gehören zu den Leiden, die als äußerst unangenehm empfunden werden. Es handelt sich dabei um eitrige Pickel oder Entzündungshöhlen, die häufig unter der Haut auftreten, aber auch weiter im Inneren des Körpers vorkommen können. Abszesse unter der Haut sehen nicht nur unschön aus, sie verursachen außerdem starke Druckschmerzen. Deswegen doktern viele Menschen selbst an den Abszessen herum und versuchen diese auszudrücken oder anders zu bekämpfen. Doch dies kann mitunter gefährlich werden. Gelangen Erreger aus der Eiteransammlung in die Blutbahnen, droht eine lebensgefährliche Sepsis (Blutvergiftung).
Abgekapselte Eiteransammlung durch Bakterien kann bedrohlich werden
Bei einem Abszess handelt es sich um einen Eiterherd, der sich vom restlichen Gewebe abkapselt. Auf diese Weise verhindert der Körper, dass sich die Entzündung weiter ausbreitet. Abszesse können unterschiedlich groß sein, von einigen Millimetern bis vielen Zentimetern. Häufig entwickelt sich ein Abszess an der Haut. Er kann an allen möglichen Körperbereichen vom Kopf über Hals, Rumpf oder Gliedmaßen bis hin zum Genital- oder Afterbereich (Analabszess) auftreten.
Die Patienten klagen über folgende typische Symptome:
- Druckempfindlichkeit
- Schmerzen
- Rötung
- Schwellung
- sichtbare Eiterkapsel
Im Inneren des Körpers können sich ebenfalls Abszesse entwickeln, beispielsweise im Mund (oft am Zahnfleisch), in der Lunge, den Bauchorganen, Knochen oder Gehirn. Schuld an einem Abszess sind normalerweise Bakterien. Diese können zum Beispiel über kleine Verletzungen unter die Haut gelangen.
Aus einem Abszess kann Eiter mitsamt Erregern in den Blutkreislauf gelangen und damit eine Sepsis verursachen. Im Normalfall bekämpft der Körper die Bakterien problemlos. Einige Voraussetzungen begünstigen jedoch stark die Entwicklung einer Sepsis:
- eigenmächtiges Herumdrücken an einem Abszess
- Schwächung des Immunsystems
- Abszess in einer Stelle im Körperinneren
Dringen Bakterien in den Blutkreislauf ein, ist häufig eine Blutvergiftung die Folge. Dabei kommt es zu einer Ausbreitung der entzündlichen Reaktion über den ganzen Körper. Betroffene zeigen in diesem Fall folgende Krankheitsanzeichen:
- Fieber
- Schüttelfrost
- beschleunigte Atmung
- erhöhte Herzschlagfrequenz
- Unwohlsein, Verwirrtheit, Desorientiertheit
Bei solchen Symptomen muss sofort ein Arzt oder ein Krankenhaus aufgesucht werden. Eine Sepsis gilt als äußerst gefährlich und muss unbedingt sofort behandelt werden. Breiten sich die Krankheitserreger weiterhin ungehindert im Blutkreislauf aus, lösen sie weitere Entzündungsreaktionen aus und es kommt es zu Organschädigungen. Es droht ein multiples Organversagen, also ein Ausfall oder eine stark gestörte Funktion von mehr als zwei lebenswichtigen Organen.
Gerade weil viele Abszesse an kleine und größere Pickel erinnern, die man selbst ausdrücken kann, werden viele Menschen selbst aktiv. Sie versuchen die Eiteransammlung selbstständig zu entfernen, indem sie die Eiterkapsel versuchen auszudrücken. Dies kann jedoch zu einem Austreten von Eiter ins Gewebe oder auch in Blutgefäße führen, woraus sich eine Sepsis entwickeln kann.
Geschwächtes Immunsystem begünstigt die Entwicklung einer Sepsis aus einem Abszess
Kommt es zum Austritt von etwas Eiter und Bakterien in das umgebende Gewebe eines Abszesses oder in ein Gefäß, dann sorgt ein funktionierendes Immunsystem dafür, diese rasch und erfolgreich zu bekämpfen. Die weitere Ausbreitung beziehungsweise eine Sepsis wird damit bei gesunden Menschen verhindert. Liegt jedoch eine Schwächung der Immunabwehr vor, dann können sich die Erreger mit wenig Gegenwehr über das Blut verteilen. Weitere Faktoren, die die Ausbreitung der Bakterien und die Entwicklung der Sepsis begünstigen, sind eine ausgedehnte Infektion des Gewebes mit großer Zahl von Krankheitskeimen, gefährliche Erregerarten (hohe Pathogenität) oder Entzündungsherde an schwer zu erreichenden Stellen im Inneren des Körpers.
Entzündungsherd in inneren Organen ist schwer beizukommen
Obwohl sich ein Großteil der Abszesse direkt unter der Haut befindet, gibt es auch Eiteransammlungen in inneren Organen. Oft machen sich die Eiterherde erst bemerkbar, wenn die Eiterkapsel geplatzt ist und ihre Bakterien in die Blutbahn entleert hat. Zuvor hat der Patient oft keine Beschwerden. Viele Betroffene suchen zudem bei Symptomen wie Abgeschlagenheit, Fieber oder allgemeinem Unwohlsein nicht unbedingt direkt einen Arzt auf. Wird die Infektion jedoch nicht umgehend behandelt, besteht Lebensgefahr. Um die Sepsis zu therapieren, muss man zunächst den Eiterherd finden. Sind Abszesse an den Nieren, der Leber oder im Gehirn vorhanden und streuen den Eiter in die Blutbahnen, müssen diese chirurgisch entfernt werden.
Bei Abszessen richtig verhalten
Besteht der Verdacht auf einen Abszess, ist es ratsam, zum Arzt zu gehen. Kleinere Abszesse unter der Haut heilen oft von alleine ab. Die Eiteransammlungen reifen innerhalb von zwei bis drei Tagen heran und platzen anschließend. Betroffene sollten aber unbedingt die Finger vom Abszess lassen, damit der Eiter nicht in den Blutkreislauf gelangt. In der Apotheke gibt es außerdem Salben, die den Reifungsprozess der Eiterkapsel unterstützen. Spätestens wenn sich der Abszess nach wenigen Tagen nicht von alleine öffnet oder größer ist, ist ein Arztbesuch notwendig. Der Arzt wird die Eiteransammlung mit einem kleinen Schnitt öffnen, insofern der Abszess reif ist. Zudem verschreibt er bei Bedarf Antibiotika, um der Entzündung entgegenzuwirken. Bei allgemeinen Krankheitszeichen wie Fieber oder Schüttelfrost muss sofort ein Arzt kontaktiert werden.
Ein Abszess an inneren Organen macht sich meist erst bemerkbar, wenn es in Hohlorgane einbricht oder in Körperhöhlen hineinragt. Entleert sich die Eiteransammlung und Bakterien gelangen in den Blutkreislauf, kommt es zu einer Blutvergiftung mit Fieber, Abgeschlagenheit und Schüttelfrost. Die Infektion muss jetzt so schnell wie möglich behandelt werden, um bleibende Schäden an den betroffenen Organen zu vermeiden.
Quellen anzeigenQuellen ausblenden
aktualisiert am 15.03.2021







